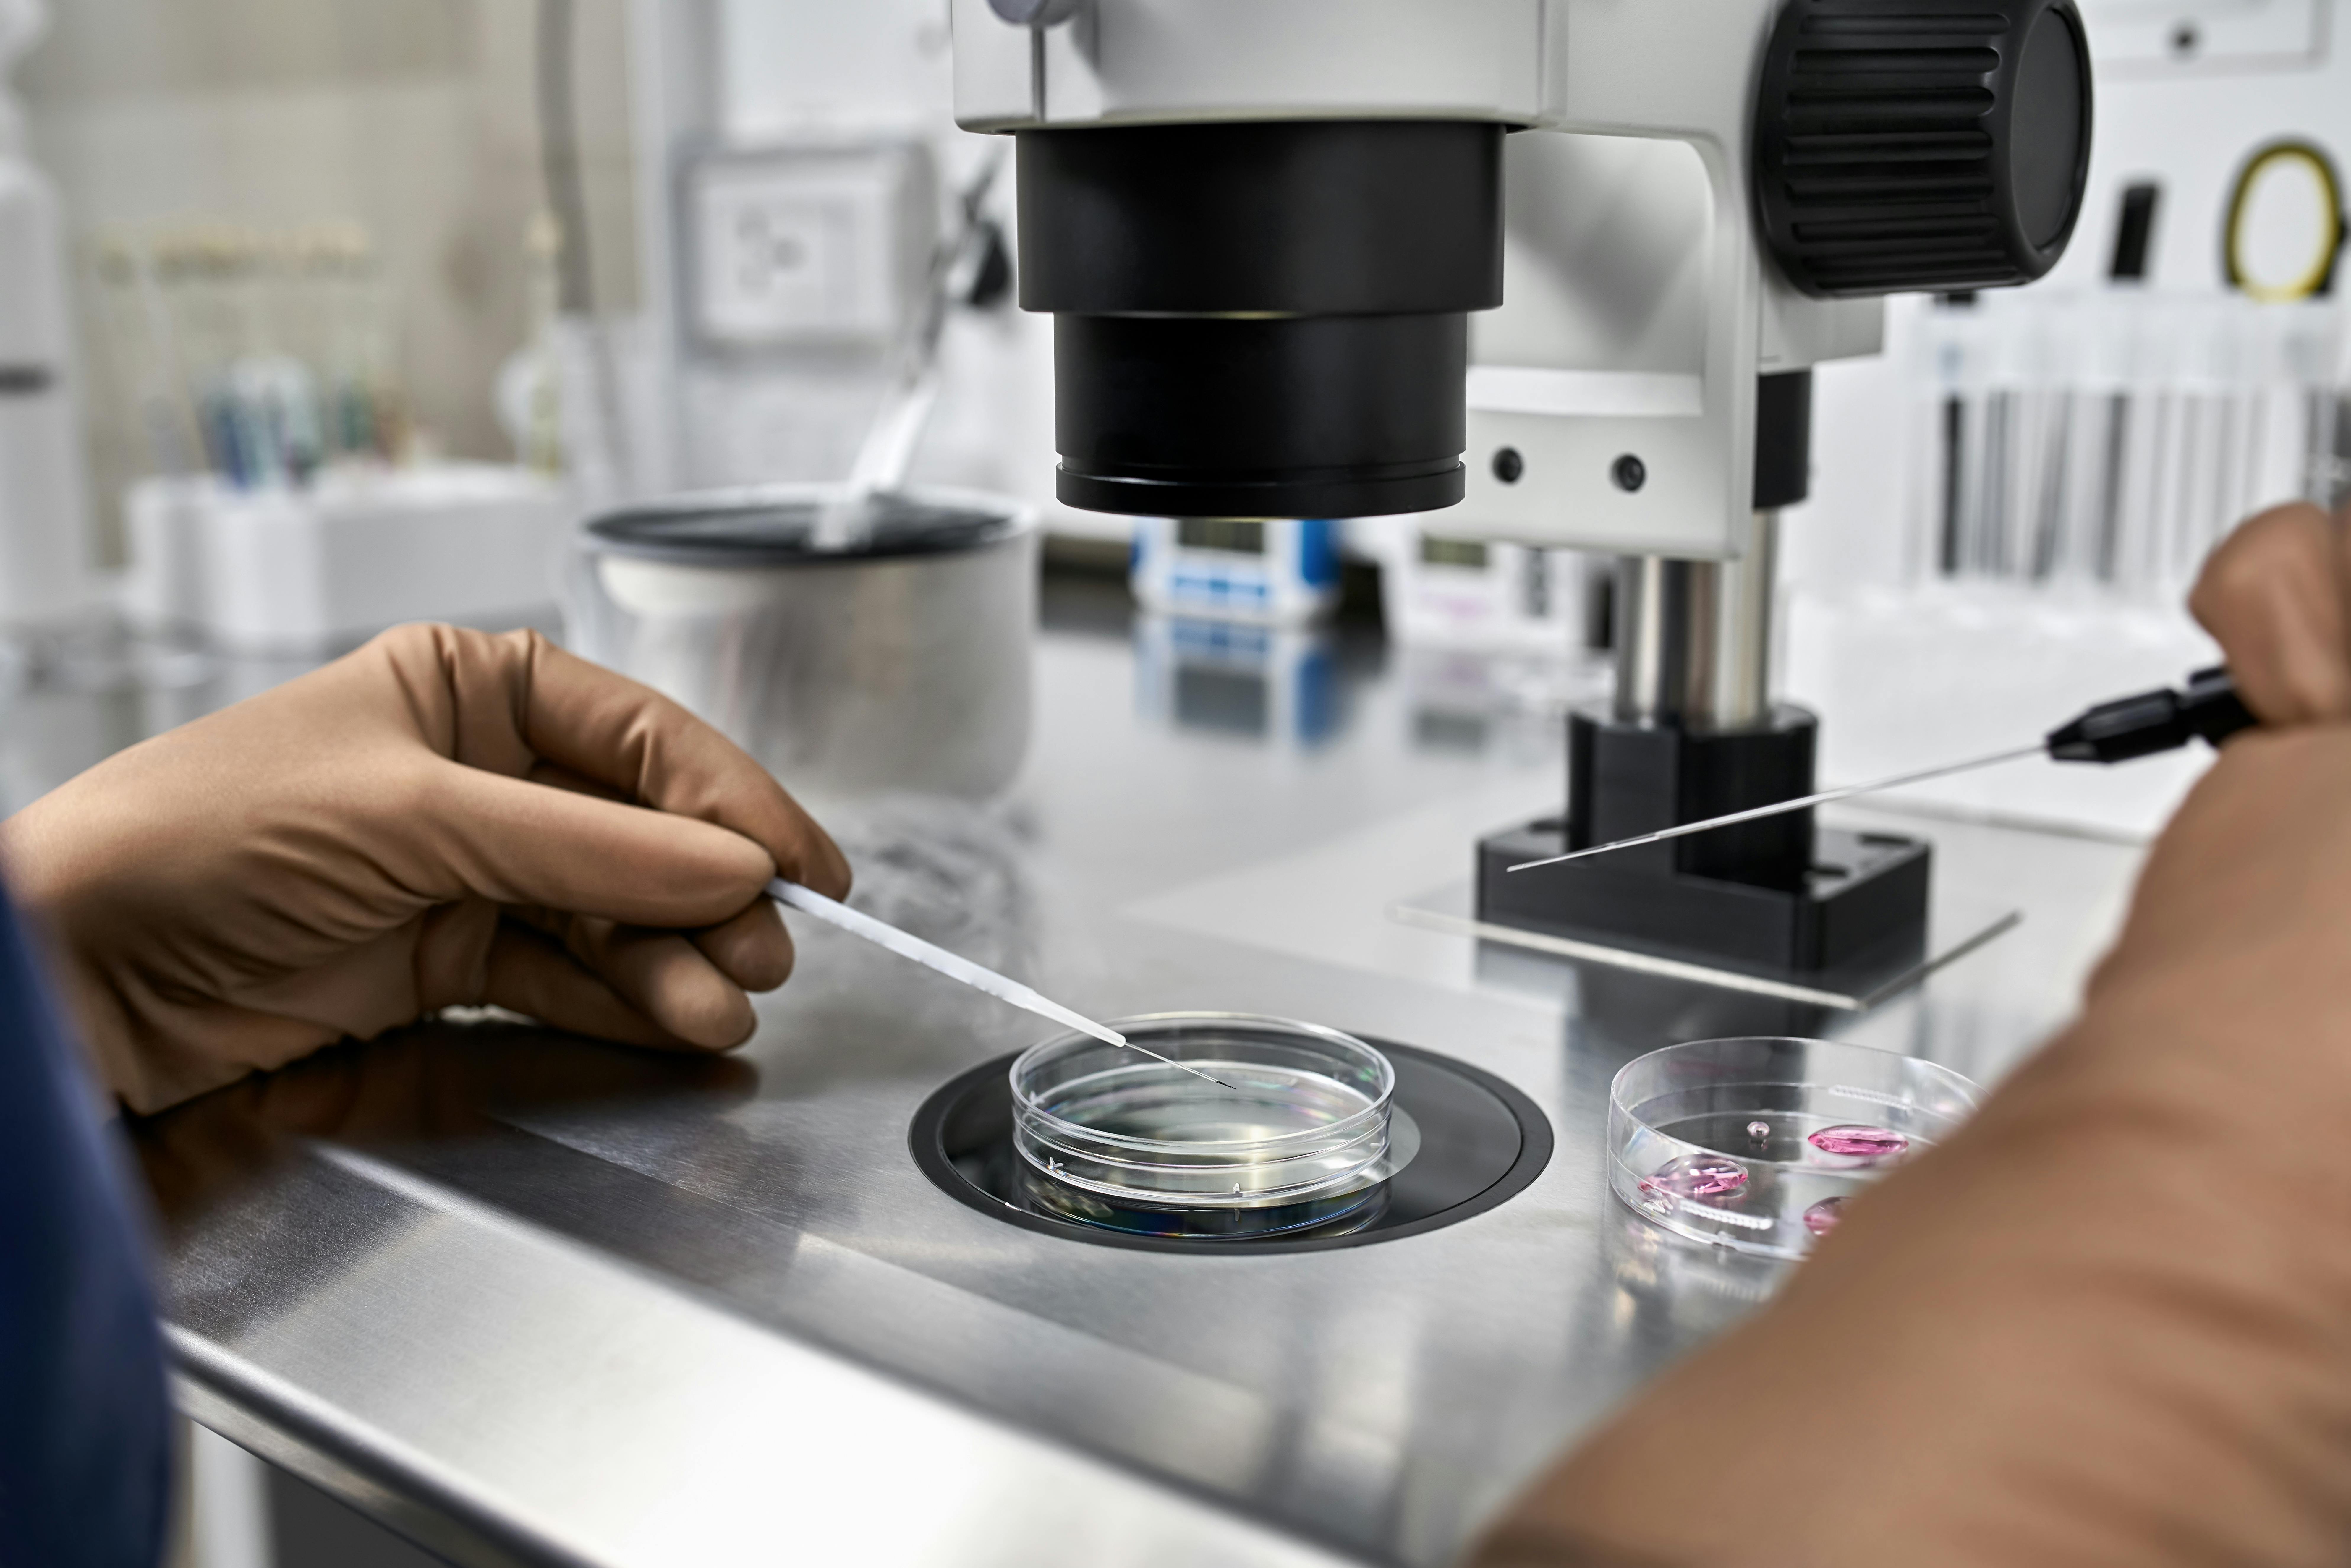
Prævention, prævention spiral, prævention uden hormoner, præventionsguide

Guide: Hvilken form for prævention skal jeg vælge?

Foto: Unsplash, Shutterstock
Der findes mange forskellige muligheder, når man gerne vil undgå graviditet og sexsygdomme. Det er vigtigt at vælge den prævention, der passer bedst til ens eget behov.
Man skal også huske, at nogle præventionsformer indeholder hormoner.
Hvis præventionsformen indeholder hormoner, kan man kun få det med recept fra lægen. Lægen undersøger og taler med dig, for at finde den præventionsform, der passer til dine behov.
Der er forskellige fordele og ulemper ved de mange mulige præventionsformer, som du kan blive klogere på her.
Præventionsguide: Hvad er den mest brugte prævention?
Det er forskelligt, hvor mange hormoner der er i de forskellige præventionsformer, og om præventionen beskytter mod sexsygdomme.
I Danmark bruger langt de fleste kvinder p-piller som prævention, og i 2020 brugte omkring 268.000 kvinder p-piller.
Tallet (link fjernet) har dog været faldende de seneste otte år.
Der findes ikke tal på, hvor mange der bruger præventionsformer, som ikke er på recept, dvs. kondomer, pessar og lignende.
Hvilken præventionsform er sikrest mod graviditet?
Valg af præventionsform er i høj grad et personligt valg, og den skal afspejle den livssituation, du befinder dig i.
Overordnet set er præventionens vigtigste formål at beskytte mod uønsket graviditet, uden at det går udover din livskvalitet, skriver Netdoktor.
Hvis man skal have svar på, hvor godt de enkelte præventionsformer beskytter, så har apoteket.dk lavet en oversigt her:
P-piller, minipiller højdosis, p-ring, p-plaster, p-stav, hormonspiral og p-sprøjte har en meget høj beskyttelse.
Kondom, minipiller lavdosis, kobberspiral, pessar og femidom har en høj beskyttelse.
Hvis du går efter et præventionsmiddel uden hormoner, der også beskytter mod sexsygdomme, er kondomet uden tvivl bedst.
I denne artikel kan du blive klogere på disse præventionsformer og ofte stillede spørgsmål:
Du kan klikke på linket for at springe til det afsnit, du gerne vil læse mere om.
- Kondom
- P-piller
- Minipiller
- Femidom
- Hormonspiral
- Kobberspiral
- P-stav
- P-ring
- P-plaster
- P-sprøjte
- Pessar
- Nødprævention
- Naturlig prævention
- Cyklusapps
- Prævention efter fødslen?
- Fremtidens prævention til mænd og kvinder
Kondom
Kondomet beskytter både mod graviditet og sexsygdomme som klamydia og HIV. Der er ifølge Sex og Samfund (link fjernet) 97 procent sikkerhed for at undgå uønsket graviditet, hvis man bruger kondom.
Alle kan købe kondomer uanset alder, og det giver meget sjældent bivirkninger. Hvis du er allergisk overfor latex, kan der dog være allergiske bivirkninger – men der findes også latex-fri kondomer.
Kondomet kan med fordel bruges af unge og voksne, der vil beskytte sig mod sexsygdomme og har skiftende partnere.
Kondomet kan også bruges af par, hvor kvinden ikke ønsker at bruge prævention med hormoner.

P-piller
P-piller indeholder to hormoner, østrogen og gestagen, og findes i forskellige former.
Normalt tager man p-piller i 21 dage og holder derefter 7 dages pause, hvor man får en blødning. P-piller forhindrer ægløsning og påvirker også slimhinden i livmoderen, så et befrugtet æg ikke kan fastsætte sig.
P-piller giver en høj grad af beskyttelse mod graviditet, men de beskytter ikke mod sexsygdomme. P-pillen virker med det samme, hvis du begynder at tage den på første dagen af din menstruation.

Hvis du glemmer at tage en p-pille, skal du tage den så hurtigt som muligt efter. Er der gået 12 timer, fra du burde have taget pillen, kan du ikke regne med fuld beskyttelse i resten af perioden.
Inden du kan få p-piller, skal du til en konsultation hos lægen, der kan udskrive en recept til dig.
Der findes desuden forskellige former for p-piller, og det inddeles efter, hvor meget gestagen, der er i p-pillen. De forskellige former hedder 2., 3. og 4.-generations gestagener.
I nyere p-piller er der desuden færre hormoner i, skriver apoteket.dk.

Progesteron: Alt du skal vide om hormonet progesteron
For nogle kommer p-pillerne dog heller ikke uden bivirkninger.
Man vil kunne opleve kvalme, brystspændinger, hovedpine, pletblødning eller humørsvingninger.
Nogle kvinder får også forhøjet blodtryk, og p-piller kan også være mindre sikre, hvis du tager en anden form for medicin ved siden af.
P-pillen fyldte i 2020 60 år og har været populær lige siden. Pillen har dog også en bagside, som femina også har dækket. Du kan læse mere om bivirkninger og mén fra p-pillen her.

P-piller fucker med din hjerne - og 11 andre ting, du skal vide
Minipiller
Minipiller indeholder kun et enkelt hormon, som er gestagen, og de tages ofte af kvinder, der ikke kan tåle p-piller. Minipiller er 98 procent sikre mod uønsket graviditet, men beskytter ikke mod sexsygdomme, skriver apoteket.dk.
Der findes både minipiller med en høj og lav koncentration af hormoner.
Lavdosis minipiller forhindrer ikke ægløsning, men danner en svært gennemtrængelig slimprop ved livmoderhalsen, så det befrugtede æg ikke kan udvikle sig.
Højdosis minipiller forhindrer derimod ægløsning.

Minipillen tages hver dag uden pause, og det anbefales, at man også tager pillen på samme tidspunkt på dagen.
Ligesom ved p-piller kan der også være bivirkninger ved minipiller, såsom uregelmæssig menstruation, humørsvingninger, pletblødning, og enkelte kvinder oplever at blive lettere deprimerede.
Femidom
Femidom er et kondom, der bruges af kvinder. Det kan med fordel bruges af kvinder, der gerne vil beskytte sig mod sexsygdomme og graviditet, og som ikke vil bruge prævention med hormoner.
Femidomet dækker indersiden af skeden, og det kræver lidt teknik at bruge, skriver apotektet.dk. Femidomet er en smule dyrere at købe end et almindeligt kondom og kan købes på de fleste apoteker.
Der er 95 procent sikkerhed mod uønsket graviditet med femidomet, og det er ikke afhængigt af en mandlig partners rejsning, skriver Sex og Samfund (link fjernet).
Ulemperne ved femidomet er, at det kan rykke sig under samleje eller presse sig ind i skeden, så man ikke er ordentligt beskyttet. Nogle femidomer er desuden lavet af latex, som nogle oplever at være allergisk overfor.
Hormonspiral
Hormonspiralen lægges op livmoderen, hvor den konstant afgiver hormonet gestagen, der forhindrer ægløsning.
Hormonspiralen kan med fordel bruges af kvinder, der ønsker en høj beskyttelse mod uønsket graviditet (Mere end 99 procent sikkerhed) og ikke ønsker at tænke over prævention.

Virkningstiden for en hormonspiral er tre til seks år, og de fleste kvinder oplever også, de får svagere og færre blødninger.
Hormonspiralen kan derfor også hjælpe kvinder, der har kraftige menstruationsblødninger.
Hormonspiralen beskytter dog ikke mod sexsygdomme, og derfor kan det være en god idé at bruge ekstra beskyttelse såsom kondom med nye partnere.
Hvis du gerne vil have en hormonspiral, skal du kontakte din egen læge. Ved en underlivsundersøgelse finder lægen ud af, om hormonspiral er en egnet præventionsform for dig. Spiralen virker allerede, når den er sat op, og den skal tjekkes en gang om året, da den kan glide ned fra livmoderen.
Der er både flere fordele og ulemper ved hormonspiral. Det er et meget sikkert præventionsmiddel, men det kan også give uregelmæssige blødninger og påvirke humøret. Femina har tidligere dækket fordele og ulemper, som du kan læse mere om her:
Kobberspiral
Kobberspiralen sidder i livmoderen på samme måde som hormonspiralen. Der er dog ikke hormoner i kobberspiralen.
Spiralen er 98 procent sikker mod uønsket graviditet, skriver apoteket.dk.
På kobberspiralen er kobber viklet rundt om et plastikskelet. Kobberet ændrer miljøet i livmoderhalsen, så sædceller bevæger sig dårligere og ikke kan nå frem og befrugte ægget. Kobberet gør også, at et befrugtet æg ikke kan sætte sig fast.
Kobberet afgives gradvist i små mængder og spiralen skal skiftes efter fem til otte år.

Kobberspiralen påvirker ikke i samme grad din cyklus som hormonspiralen, men den giver ofte en kraftigere menstruation.
Kobberspiralen kan desuden give større risiko for underlivsbetændelse.

Kobberspiral: Alt hvad du skal vide om den hormonfrie spiral
P-stav
P-staven kaldes også for en hormonstav, da den indeholder hormonet gestagen. Lægen opererer staven ind under huden på indersiden af overarmen. Staven har cirka en længe på fire centimeter og en diameter på to millimeter.
Den virker i tre år og giver en høj grad af beskyttelse mod uønsket graviditet. Staven afgiver en lille smule hormon ud i kroppen, der forhindrer ægløsning.
P-staven fås på recept hos lægen, og derefter bestiller man tid til en indlægning af p-staven i armen. Staven kan også tages ud før tid med et lille indgreb, hvis man ikke vil have den længere.
P-staven kan med fordel bruges af dig, der ikke ønsker at tænke på prævention i hverdagen, skriver apoteket.dk.
Der er dog også ulemper ved p-staven, der ofte giver uregelmæssige blødninger, uren hud, hovedpine, humørsvingninger og vægtøgning. P-staven beskytter heller ikke mod sexsygdomme.
P-ring
P-ringen er en lille ring, der indeholder østrogen og gestagen, som forhindrer ægløsning.
Du sætter selv ringen op i skeden, og når ringen er blevet placeret rigtig, skal den blive siddende i 21 dage. Efter 21 dage tager du ringen ud og holder en pause på syv dage, hvor du vil få menstruation.
Hvis du sætter p-ringen op på første dag af menstruationen, er du beskyttet fra den dag.
P-ringen har høj beskyttelse mod graviditet, men beskytter ikke mod sexsygdomme. Hormonerne fra p-ringen kan desuden give bivirkninger som hovedpine, humørsvingninger, kvalme og brystspændinger.
Du kan læse mere om p-ringen, og hvordan den virker hos Sex og Samfund. (link fjernet)
P-plaster
P-plasteret bliver også kaldt for præventionsplaster og indeholder gestagen og østrogen, der forhindrer ægløsning.
Hormonerne i p-plasteret optages gennem huden, og efter syv dage skal man skifte plasteret. Efter 21 dage med plasteret skal man holde syv dage uden plaster, hvor man vil få menstruation.
Plasteret kan placeres på forskellige steder på kroppen (dog ikke på brysterne), og du kan også gå i svømmehal og sauna med plasteret på.
P-plasteret er en sikker præventionsform, og det eneste du skal sørge for er, at skifte plasteret hver syvende dag.
Hormonerne fra p-plasteret kan dog give bivirkninger som hovedpine, humørsvingninger, kvalme og brystspændinger.
Plasteret beskytter heller ikke mod sexsygdomme.
Du kan læse mere om p-plasteret, og hvordan det virker hos Sex og Samfund (link fjernet).
P-sprøjte
P-sprøjten indeholder hormonet gestagen, der forhindrer eller reducerer ægløsning. Sprøjten gives hos lægen hver tredje måned.
Fordelen ved p-sprøjten er, at man ikke skal huske sig selv på at tage en pille hver dag.
P-sprøjten beskytter dog ikke mod sexsygdomme, og der går normalt otte til ti måneder, efter man er stoppet med p-sprøjten, til man kan blive gravid.
Da p-sprøjten indeholder gestagen, kan den give nogle af de samme bivirkninger som p-piller, p-stav og p-ring, skriver sundhed.dk.

Hos en ud af fem kvinder forsvinder menstruationen helt, når de tager p-sprøjten. Metoden er desuden oftest brugt af kvinder, der af den ene eller anden grund ikke kan bruge nogen andre beskyttelsesmuligheder, skriver Sexlinien.dk.
Pessar
Et pessar er lavet af medicinsk silikone og har en fast ring i kanten, der sættes op foran livmodermunden. Pessaret er 98 procent sikker mod uønsket graviditet, men det beskytter ikke mod sexsygdomme, skriver apoteket.dk.
Pessaret anvendes altid med pessarcreme, og når det er anbragt rigtigt, lukker det af for, at sædceller kan trænge ind og befrugte ægget.

De fleste kvinder kan bruge pessar, og ved en underlivsundersøgelse hos lægen finder du ud af, om pessaret er egnet til dig.
Det er vigtigt, at pessaret passer til dig og sidder rigtigt – du kan altid gå til din læge, hvis du er i tvivl. Pessaret kan sættes op et par timer inden samleje og kan tidligst fjernes seks timer efter samleje.
Pessaret giver ingen hormonelle bivirkninger, ændrer ikke hormonbalancen og kræver kun få lægebesøg.
Nødprævention
Nødprævention kaldes ofte i daglig tale for “fortrydelsespille”. Nødprævention er oftest baseret på piller med hormon, der hindrer eller udskyder ægløsningen, så en befrugtning kan undgås.
Pillen tages, hvis man har mistanke om, at den prævention, man plejer at bruge, har svigtet, eller hvis man har haft ubeskyttet sex.
Det er vigtigt, at pillen tages hurtigt efter det ubeskyttede samleje, for effekten falder jo længere tid, der går.
Du kan købe nødprævention på apoteket uden recept. Hvis de har lukket, kan du gå på et døgnapotek eller til lægevagten.
Når du tager nødprævention, kan menstruationen komme tidligere eller senere end forventet. Uanset hvornår den kommer, bør du tage en graviditetstest, tre uger efter du har taget pillen.
Nogle kvinder oplever også kvalme, opkastninger, svimmelhed og hovedpine, efter de har taget pillen. Bivirkningerne forsvinder normalt inden for 48 timer, skriver Sex og Samfund (link fjernet).
Naturlig prævention
Tal fra Sundhedsstyrelsen viser, at flere og flere kvinder fravælger hormonprævention. Mellem 2010 og 2020 er antallet af brugere af hormonprævention faldet med knap 30 procent.
Flere og flere kvinder søger efter naturlig prævention, men det er vigtigt at huske på, at det ikke altid er de mest sikre metoder, hvis man vil undgå at blive gravid.
Nogle benytter sig af afbrudt samleje, men ifølge sundhed.dk resulterer det i graviditet for 20 procent af de par, der benytter metoden.
Metoden skaber også usikkerhed omkring, om manden nåede at trække sig tilbage i tide. Der er altså høj risiko for graviditet og sexsygdomme.
Andre benytter sig af ”sikre perioder”, som betyder, at man ikke har samleje i perioden omkring kvindens ægløsning. Mulighederne for at blive gravid er de sidste 4-5 dage før ægløsning og 2-3 dage efter ægløsning.
Med metoden er der dog høj risiko for at blive gravid, og i 25 procent at tilfældene bliver par gravide, når de bruger metoden, skriver sundhed.dk. Sikre perioder beskytter heller ikke mod sexsygdomme.
Cyklusapps
Forskellige cyklusapps og præventionsapps kan også fortælle dig, hvornår du har din ægløsning, og hvornår det er en god idé at undgå samleje, hvis du ikke vil være gravid.
En af dem er ”Natural Cycles”, som er godkendt som præventionsmiddel i Europa. Hver morgen måler du din temperatur med et lille termometer, som du stikker ind under tungen.
Temperaturen og anden data om pletblødning, sygdom osv. taster du ind i appen, og den giver dig et vindue på seks dage, hvor du har mulighed for at blive gravid.
Femina har skrevet om, hvordan appen virker her:

Skal din temperatur beskytte dig mod uønsket graviditet i fremtiden?
Hvilken prævention påvirker menstruationen?
Der er flere præventionsmetoder, der kan påvirke menstruationen på forskellige måder. Her er nogle af de mest almindelige:
- Hormonspiral: Den her type spiral kan reducere menstruationsblødninger betydeligt og i nogle tilfælde stoppe menstruationen helt efter nogle måneder.
- P-piller: De her piller indeholder både østrogen og progestin og kan gøre menstruationerne lettere, kortere og mere regelmæssige. De kan også reducere menstruationssmerter.
- Minipiller: De her piller indeholder kun progestin og kan medføre, at menstruationerne bliver uregelmæssige eller helt stopper.
- P-stav: Den her lille stav, der placeres under huden på armen, frigiver progestin og kan gøre menstruationerne lettere eller få dem til at stoppe helt.
- P-ring: Ringen frigiver østrogen og progestin og kan gøre menstruationerne lettere, kortere og mere regelmæssige.
- P-plaster: Det her plaster frigiver hormoner gennem huden og har lignende virkninger på menstruationen som p-piller.
- P-sprøjte: Den her sprøjte gives hver tredje måned og kan gøre menstruationerne uregelmæssige eller få dem til at stoppe.
- Kobberspiral: Modsat de hormonelle metoder, kan kobberspiralen gøre menstruationerne kraftigere og længere samt øge menstruationssmerterne.
Kilde: minprævention.dk
Prævention efter fødslen?
Det er meget individuelt, hvornår man begynder at have samleje igen efter at have født, og hvilken slags prævention, man bruger.
Det er dog en god idé at bruge kondom, så længe du bløder efter fødslen. Hvis du er i tvivl om, hvilken slags prævention du vil bruge efter fødslen, kan du altid kontakte din læge.
Ifølge sundhed.dk vil ægløsningen som regel komme efter seks måneder, hvis man ammer. Hvis man ikke ammer, kan ægløsningen allerede komme inden for en måned.
Nogle vælger at bruge amningen som en præventionsmetode. Hvis man ammer fast, kan det skubbe ægløsningen, og chancen for at blive gravid er derfor mindre.
Selv om man bliver ved med at amme, så vil ægløsningen dog oftest komme efter seks måneder.
Sundhed.dk pointerer dog også, at det ikke er en sikker metode, da man ikke kan vide sig sikker på, hvornår ægløsningen kommer igen.
Fremtidens prævention til mænd og kvinder
Langt de fleste præventionsformer er til kvinder, og en af grundene til det er, at det er kulturelt indlejret i os, at prævention er kvindens ansvar.
En anden grund er, at medicinalfirmaerne ikke tror på, at eksempelvis p-piller til mænd kan sælge.
Det fortæller Christian Graugaard, som er læge og professor ved Sexologisk Forskningscenter på Aalborg Universitet, i en i et interview med femina.
På trods af det er amerikanske forskere i gang med at udvikle en p-pille til mænd. Produktet hedder Triptonide og er baseret på kinesiske urter, der hæmmer sædcellens evne til at svømme.
Du kan læse mere om p-pillen til mænd og fremtidens prævention til både mænd og kvinder i artiklen nedenfor.

Bliver p-piller til mænd fremtidens prævention?
Udvalgt indhold

Er du i et forhold og har fået et crush på en anden? Det her skal du være opmærksom på, siger parterapeuten

Sådan bliver han forelsket i dig: Mange tør ikke taget skridtet
